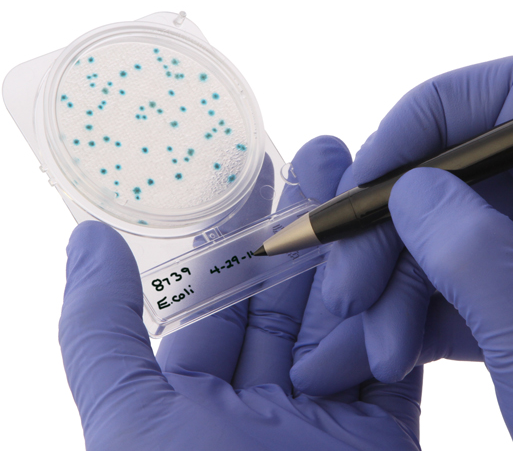
Compact Dry

Santa Maria, California, Jan. 5, 2015 (GLOBE NEWSWIRE) -- Hardy Diagnostics, an FDA licensed and ISO certified biomedical manufacturer, is pleased to announce the release of Compact Dry, a simple method for cultivating and counting common food- borne microorganisms.
Compact Dry is a self-contained device containing a membrane matrix saturated with a culture medium and a gelling agent, and then dried. A diluted food sample (1mL) is added to the center of the device, which diffuses automatically and evenly throughout the plate. The device is then incubated, after which a technician counts the colonies
Compact Dry is available in many formats: Total Viable Count (TC), E. coli & Coliforms Count (EC), Coliforms Count (CF), S. aureus (X-SA), Yeast and Mold Count (YM), Bacillus cereus (X-BC), V. parahaemolyticus (VP), Salmonella (SL) and Listeria (LS). The devices are simple to inoculate, have a long shelf life (18 months) except SL (16 months) and LS (10 months), can be stored at room temperature, have large write-on area, and can be easily stacked. If further testing or sub-culturing is needed, the lid is easily removed and colonies can be picked with ease. The Compact Dry has earned multiple performance certifications, such as AOAC and MicroVal.
ABOUT HARDY DIAGNOSTICS
Hardy Diagnostics, an FDA licensed manufacturer of medical devices for microbiological testing with an ISO 13485 certified Quality Management System. The company manufactures over 3,500 products for the culture and identification of bacteria and fungi from its California and Ohio manufacturing facilities. Headquartered in Santa Maria, CA, Hardy Diagnostics services over 8,000 laboratories throughout the nation.
The company, which is now employee owned, was founded in 1980 by Jay Hardy, a Clinical Laboratory Scientist from Santa Barbara, CA. Today, Hardy Diagnostics maintains nine distribution centers throughout the U.S. and exports products to over 60 foreign distributors.
The company's mission is to partner with its laboratory customers to prevent and diagnose disease. For more information on products and services and a complete profile on the company's history, visit www.HardyDiagnostics.com.
A photo accompanying this release is available at:
http://www.globenewswire.com/newsroom/prs/?pkgid=29784